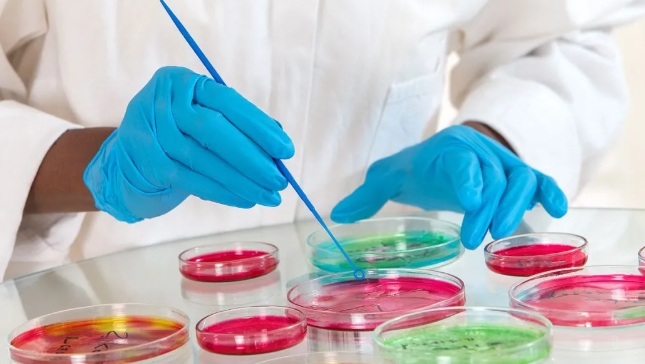

01樣品的制備和稀釋倍數(shù)的選擇
對于冰凍的樣品,在接種前要放到0~4℃的冰箱中解凍。固體樣品要用滅菌刀或鑷子從不同部位采取試驗材料并混合,在無菌操作下充分研細,混勻,做成均勻稀釋液。樣品制備的整個過程都應(yīng)在無菌狀態(tài)下進行,以防污染。任何樣品在打開包裝前,都要在取樣開口處的周圍表面進行消毒。
錯誤操作是:冰凍樣品的解凍時間過長,導(dǎo)致細菌增殖,使實測結(jié)果偏高;固體樣品取樣不均衡,稀釋液未充分混勻,使所測結(jié)果準確度降低;取樣時未進行外包裝消毒,引起樣品污染。
充氣飲料應(yīng)在無菌條件下進行排氣;酸性樣品用經(jīng)過滅菌的20~30% 碳酸鈉溶液調(diào)整pH值到中性;含鹽量較高的樣品應(yīng)用滅菌蒸餾水進行稀釋。
錯誤操作是:充氣飲料未經(jīng)排氣,使樣品接種量偏低;酸性樣品未調(diào)pH值,使不適合酸性狀態(tài)下生長的細菌受抑制;高鹽樣品仍用生理鹽水進行稀釋,使不適于高鹽狀態(tài)下生長的細菌受抑制,結(jié)果均使實測值偏低。
不同的食品其「菌落總數(shù)」的檢出限量也不一致。醬油、奶制品、熟肉制品等細菌含量一般偏高,稀釋度可相應(yīng)選擇較大的,如1:100 和1:1000 等,而飲料、糕點類樣品中細菌量偏低,稀釋度應(yīng)選擇較小的,如液體樣品可選原樣,固體樣品選1:10 等。
錯誤操作是:選擇的稀釋度過大,使得菌落生長稀少,或者稀釋度過小,菌落生長密度高,難以計數(shù),導(dǎo)致實測結(jié)果或偏高或偏低。
02 接種、培養(yǎng)過程中應(yīng)注意的問題
接種時,需要使用管口上部塞有脫脂棉球的且經(jīng)過高溫烘烤的移液管吸取稀釋液,以免發(fā)生交叉污染。稀釋液加入平皿后,應(yīng)在盡可能快的時間內(nèi)傾入瓊脂,并立即在桌面上推旋平皿,使樣液與瓊脂混合均勻,切忌推旋動作過大,將瓊脂濺到平皿蓋上,影響測定結(jié)果。
平皿內(nèi)瓊脂凝固后,不要長久放置后才翻轉(zhuǎn)平皿培養(yǎng),而應(yīng)在瓊脂凝固后立即將平皿翻轉(zhuǎn)予以培養(yǎng),這樣可避免菌落蔓延生長,難以計數(shù)。
配制、分裝稀釋液或傾注平板不能在日光直射下進行,以防強烈的日光將細菌殺死。
03滅菌消毒過程中應(yīng)注意的問題
(1)菌落檢測過程中所用到的一切用具和培養(yǎng)基都需要經(jīng)過滅菌程序。
(2)在實驗進行前,還需要經(jīng)過紫外燈照射殺菌,接種室需經(jīng)常用消毒液進行地面、墻面以及桌面的消毒處理。
(3)檢測人員的實驗服也需經(jīng)常用消毒液浸泡消毒。
(4)凡是能在高溫下烘烤的器皿、器械等都應(yīng)使用專用紙包好并且在170℃烘烤3小時以上,以確保徹底滅菌。
(5)培養(yǎng)基和液體試劑,則要在高壓鍋內(nèi)進行滅菌。
在培養(yǎng)時,恒溫培養(yǎng)箱的溫度不能過高,以免出現(xiàn)蔓延生菌的趨勢,但也要防止因通風(fēng)和空氣循環(huán)而造成的培養(yǎng)基太干,而影響細菌的正常生長。
高滅菌效果的好壞可通過空白試驗確定。空白試驗有空氣空白、稀釋用水空白、器皿空白等,完美的空白試驗平板上應(yīng)該無細菌生長。

04菌落計數(shù)和檢測結(jié)果報告中應(yīng)注意的問題
菌落計數(shù)在完成培養(yǎng)后應(yīng)立即進行,以防細菌繼續(xù)生長蔓延影響實測結(jié)果。由于不小心、視力疲勞或菌落沒有辨認好,均可導(dǎo)致錯誤的結(jié)果,因此,檢測人員在計數(shù)時應(yīng)采取多人同時進行計數(shù)的方法,以避免這種情況造成的誤差。
注:如果所有稀釋度的平板均無細菌生長,則檢測報告應(yīng)以最低稀釋度報出,如最低稀釋度為1,則報為<1;若最低稀釋度為1:10,則報為<10,而不能報為「未檢出」。
為避免在人工菌落計數(shù)時導(dǎo)致的錯誤結(jié)果,我們還可以通過使用全自動菌落計數(shù)儀替代傳統(tǒng)的人工肉眼計數(shù)的方法,其可以大大節(jié)省時間、提高準確度,并且實現(xiàn)數(shù)字化管理,讓您的操作更簡單,結(jié)果更準確。
以上就是小編為大家介紹的菌落總數(shù)檢測操作4大常見誤區(qū)!你都清楚?的全部內(nèi)容,如果大家還對相關(guān)的內(nèi)容感興趣,請持續(xù)關(guān)注上海??藸?。
本文標(biāo)題:菌落總數(shù)檢測操作4大常見誤區(qū)!你都清楚? 地址:/news/wenti/274.html















客服1